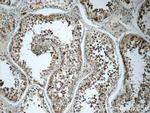
SPATA7 Antibody in Immunohistochemistry (Paraffin) (IHC (P))

Search
Proteintech
SPATA7 Polyclonal Antibody
{{$productOrderCtrl.translations['antibody.pdp.commerceCard.promotion.promotions']}}
{{$productOrderCtrl.translations['antibody.pdp.commerceCard.promotion.viewpromo']}}
{{$productOrderCtrl.translations['antibody.pdp.commerceCard.promotion.promocode']}}: {{promo.promoCode}} {{promo.promoTitle}} {{promo.promoDescription}}. {{$productOrderCtrl.translations['antibody.pdp.commerceCard.promotion.learnmore']}}
产品信息
12020-1-AP
种属反应
已发表种属
宿主/亚型
分类
类型
抗原
偶联物
形式
浓度
规格
纯化类型
保存液
内含物
保存条件
运输条件
产品详细信息
The antibody can recognize all 3 isoforms of SPATA7.
Immunogen sequence: SFLSQYRYY TPAKRKKDFT DQRIEAETQT ELSFKSELGT AETKNMTDSE MNIKQASNCV TYDAKEKIAP LPLEGHDSTW DEIKDDALQH SSPRAMCQYS LKPPSTRKIY SDEEELLYLS FIEDVTDEIL KLGLFSNRFL ERLFERHIKQ NKHLEEEKMR HLLHVLKVDL GCTSEENSVK QNDVDMLNVF DFEKAGNSEP NELKNESEVT IQQERQQYQK ALDMLLSAPK DENEIFPSPT EFFMPIYKSK HSEGVIIQQV NDETNLETST LDENHPSISD SLTDRETSVN VIEGDSDPEK VEISNGLCGL NTSPSQSVQF SSVKGDNNHD MELSTLKIME MSIEDCPLDV (120-468 aa encoded by BC008656)
靶标信息
The function of the SPATA7 protein remains unknown.
仅用于科研。不用于诊断过程。未经明确授权不得转售。
生物信息学
蛋白别名: epididymis secretory protein Li 296; epididymis secretory sperm binding protein; fertility related protein WMP1; fertility-related protein WMP1; HSD-3.1; SPATA7; sperm DNA no.3; Spermatogenesis-associated protein 7; Spermatogenesis-associated protein 7 homolog; Spermatogenesis-associated protein HSD3; unnamed protein product
基因别名: AI661438; B230306G18Rik; HEL-S-296; HSD-3.1; HSD3; LCA3; RP94; RSD-3; SPATA7; Wmp1
UniProt ID: (Human) Q9P0W8, (Mouse) Q80VP2
Entrez Gene ID: (Human) 55812, (Mouse) 104871, (Rat) 192225